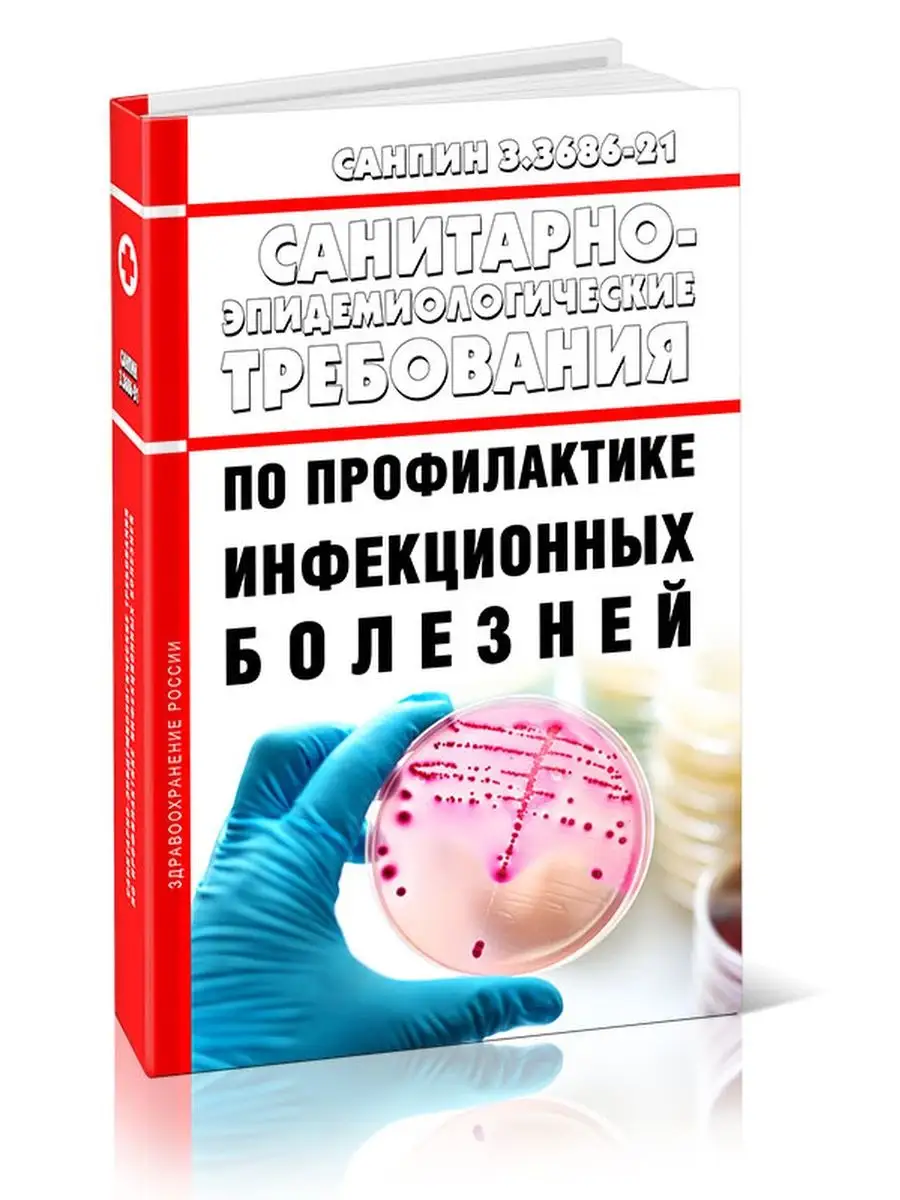

Внутрибольничные инфекции санпин
Консультирование родителей по вопросам воспитания детей
Чем удобны банковские карты
Fish the dish
Тест в втб инвестиции ответы
Таблица размеров винтов
Насадка на смазочный шприц
Burak yeter life
Теория зоне ближайшего развития ребенка
Балансирующее зарядное
Очаговая фовеолярная гиперплазия что это
Обстановка в судже и коренево
Скелет черепа птиц
A few flowers
Внутрибольничные инфекции санпин 120 фото